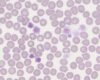

Per la diagnosi in caso di forma neurologica data da virus erpetici (di solito causata dal sierotipo 1 variante neuro-logica, (D752) ma in alcuni casi anche dal sierotipo senza variante specifica, oppure dal sierotipo 4) è indicata la PCR su liquido cefalorachidiano, in quanto il virus si localizza nel tessuto nervoso.
Negli ultimi anni si è verificato un aumento dell’incidenza di numerose malattie infettive, sia a causa delle modificazioni climatiche che hanno dilatato i tempi e le zone di sopravvivenza degli eventuali artropodi vettori, che per effetto dell’aumento della vita media dei nostri pazienti, e delle intense movimentazioni (anche internazionali) degli equini sportivi
Il virus della Blue Tongue (o Febbre catarrale) è un Orbivirus della famiglia delle Reoviridae, RNA virus a doppio filamento senza envelope, presente in 24 sierotipi (1 – 24) a trasmissione tramite vettori (Culex, descritte anche le zecche degli ovini e la via iatrogena), che interessa sia ruminanti domestici che selvatici.
Sappiamo quanto la profilassi vaccinale rappresenti un presidio importante per salvaguardare la salute del cavallo e preservarlo da quelle patologie per le quali non disponiamo di una cura efficace ma possiamo solamente offrire delle terapie sintomatiche di sostegno.
La gravidanza nei camelidi dura in media circa 340 gg, con oscillazioni dai 320 gg fino a oltre 365 gg.
I puledri possono mostrare ipotiroidismo già alla nascita e persino nell’utero. Questa situazione può portare a gestazioni prolungate (oltre i 365 gg) o a dismaturità, in quanto gli ormoni tiroidei sono coinvolti nell’organogenesi.
I problemi di fertilità nelle cavalle possono essere causati dalla colonizzazione batterica degli organi genitali. Durante l'accoppiamento naturale, i batteri possono poi causare infezioni nello stallone.
Nelle cavalle da riproduzione, le infezioni del tratto genitale possono portare principalmente a infertilità, aborti e alla nascita di puledri deboli con setticemia.
I camelidi possiedono un metabolismo particolarmente delicato e risentono dello stress (per le manipolazioni, il contenimento o i cambi ambientali) molto di più rispetto agli altri animali domestici.
Le placentiti equine costituiscono una sfida importante per gli ippiatri che si occupano di riproduzione.
Le patologie tiroidee nella specie equina non sono frequenti e spesso rappresentano una componente di patologie più complesse che riguardano l’asse ipotalamo-pituitaria che, attraverso la modulazione della secrezione di TRH e TSH, coinvolgono secondariamente la tiroide, oppure possono derivare da carenze alimentari (iodio) che influenzano la produzione ormonale.
Congresso annuale dell’European College of Equine Internal Medicine
Negli ultimi anni il numero degli alpaca e dei lama allevati e anche il loro numero assoluto è in costante aumento.
2024
Le epatopatie nel cavallo possono manifestarsi con diversi sintomi aspecifici, di solito di carattere cronico...
L’infezione da Clostridium botulinum e la conseguente intossicazione data dalle tossine prodotte da questo batterio causa una patologia molto seria nel cavallo ed in altri animali, compreso l’uomo.
L’infezione da Clostridium tetani nel cavallo causa una grave malattie la cui cura è solamente sintomatica e per la quale possiamo solo attuare delle efficaci misure di prevenzione.
Le patologie epato-pancreatiche nei camelidi hanno un’importanza notevole nel monitoraggio delle malattie metaboliche di questi animali.
L’esame dell’occhio nel cavallo richiede uno strumentario adeguato e l’utilizzo di una corretta sedazione ed anestesia locale, così da poter effettuare in sicurezza sia l’esame clinico che gli accertamenti di laboratorio che molto spesso risultano indispensabili per una corretta diagnosi.
Sebbene i cavalli non siano cani di grossa taglia, esistono molte procedure, come gli esami dermatologici, che sono molto simili a quelli utilizzate nei cani.
Nell’arco di queste stagioni (dalla primavera all’autunno), le ovaie delle cavalle sono soggette a cambiamenti fisiologici legati al ciclo, che si manifestano nello sviluppo e nel rimodellamento dei corpi funzionali e nella variazione delle dimensioni.
Nel gruppo delle Spirochete, microrganismi gram negativi elicoidali dotati di flagelli, possiamo annoverare anche Borrelia burgdorferi, responsabile della Malattia di Lyme nell’equino.
I veterinari hanno a disposizione un’ampia gamma di metodi di rilevamento diversi per la diagnosi delle malattie infettive.
Vi sono quattro specie di camelidi sudamericani: guanaco (Lama guanicoe), vigogna (Vicugna vicugna), lama (Lama glama) ed alpaca (Vicugna pacos).
Alla “Kester News Hour” sono state presentate diverse importanti pubblicazioni dell'anno precedente: con lo sfondo della valutazione del rischio di laminite dopo somministrazione di cortisone, Boger et al. studiarono l’effetto di una singola iniezione intraarticolare (i.a.) di triamcinolone acetato (TA) sulle concentrazioni di glucosio nel sangue e di insulina nei cavalli.
L'autrice ha affrontato il tema della perdita di peso cronica nei cavalli adulti e ha discusso in modo più dettagliato la "inflammatory bowel disease" (IBD).
Le leptospire sono microrganismi spiraliformi, molto sottili, gram negativi, asporigeni, dotati di endoflagelli, di una parete e di una membrana con lipopolisaccaridi, appartenenti al phylum Spirochete.
L’anemia infettiva equina è una malattia virale riconosciuta fin dai primi del 900 per cui non vi è al momento alcuna cura né vaccino, trattandosi di un Retrovirus della sottofamiglia dei Lentivirus (virus a RNA come i Retrovirus umani responsabili dell’HIV).
2023
Le patologie intestinali rappresentano i casi più frequenti di consulto nella pratica veterinaria, a parte i problemi ortopedici. Sebbene i tumori primari appaiano rari, quelli maggiormente riscontrati sono i linfomi, i tumori a cellule fusiformi e gli adenocarcinomi.
Le patologie ortopediche dello sviluppo del puledro comprendono una serie di disturbi della maturazione dell’osso e delle cartilagini di accrescimento ed articolari, tutte riunite nell’acronimo inglese DOD (Developmental Othopedic Diseases).
Il virus West Nile (WNV) è stato scoperto e descritto in Africa negli anni '30.
La laminite è una grave patologia che coinvolge le lamine del piede equino.
Negli ultimi anni la diagnostica di laboratorio ha sviluppato moltissimo la possibilità di effettuare esami rapidi, precisi, veloci in modo da poter prendere delle decisioni importanti per la vita del paziente attraverso l’utilizzo di moderni macchinari portatili.
Gli esperti hanno discusso a proposito di alcuni studi recenti che indicano come riconoscere i soggetti portatori asintomatici.
Non sono molti i parametri ematologici che possono aiutare l’ippiatra nella diagnosi di questa affezione o che possono agevolarlo nel monitoraggio della terapia e nell’evoluzione della patologia.
Per asma equina si intende una sindrome che comprende una serie di sintomi clinici caratterizzati da broncospasmo, tosse, produzione di muco, infiammazione, innescati da antigeni ambientali volatili che vengono in contatto con le vie aeree.
Il puledro nasce con un sistema immunitario immaturo ed assume le prime immunoglobuline tramite il colostro materno.
L’emostasi è il risultato di un delicato equilibrio tra fattori della coagulazione, fattori anticoagulanti e fibrinolitici: infatti possiamo distinguere un’emostasi primaria che coinvolge le piastrine, un’emostasi secondaria che coinvolge la formazione del coagulo di fibrina e la fibrinolisi che lo modula.
2022
Questo gruppo di patologie nel cavallo comprende malattie parassitarie croniche, ulcere gastrointestinali, malattie infiammatorie croniche e linfoma del tratto alimentare.
Gli allevatori sanno da sempre che il momento del parto nella fattrice non sempre è di facile rilevazione, soprattutto nelle primipare.
In condizioni di normalità, lo svezzamento di un puledro in salute avviene intorno ai 6 mesi di vita, oltre questo termine il latte materno comincia infatti a perdere importanza come intake calorico e a ridursi in quantità e qualità.
Negli ultimi anni, la diagnostica di laboratorio si è notevolmente arricchita di sempre nuovi test e procedure. Questo è particolarmente evidente soprattutto per quanto concerne l’esame delle feci sia nel puledro che nell’adulto. Vediamo nel dettaglio cosa è possibile prendere in esame in caso di diarrea nel puledro - neonato e fino allo svezzamento.
I trombociti, noti anche come piastrine, sono una parte importante della coagulazione del sangue.
Sappiamo che il parto ed il periparto nella specie equina costituiscono un momento importantissimo e delicatissimo, capace di condizionare la vita futura del puledro: questo infatti nasce immunocompetente ma senza immunoglobuline
A causa delle limitate disponibilità di ricovero, nella clinica del cavallo ci si trova con frequenza nella necessità di allestire una fluidoterapia, anche aggressiva, in campo.
La valutazione delle malattie respiratorie degli equini si basa sull'anamnesi, sull'esame clinico, sui reperti endoscopici e sui test di funzionalità polmonare;
Il veterinario ippiatra che si trova di fronte ad un soggetto in decubito deve affrontare una vera e propria sfida diagnostica a causa delle scarse possibilità di una visita clinica esauriente e l’estrema difficoltà nell’esecuzione di approfondimenti strumentali. Vediamo come il laboratorio può aiutare il veterinario clinico nella gestione di questi pazienti particolari.
La biopsia uterina permette un’efficace diagnostica di laboratorio nelle fattrici problematiche o nelle cavalle sportive che si intende mettere in attività riproduttiva.
2021
L’esame delle urine nella specie equina deve sempre costituire parte integrante della valutazione della funzionalità dell’emuntorio in tutti quei casi in cui si rilevino grosse anormalità della produzione e delle caratteristiche chimico-fisiche dell’ urina stessa, nella frequenza e nelle caratteristiche della minzione ed importanti squilibri nell’assunzione di acqua.
La nomenclatura delle malattie respiratorie degli equini è stata recentemente rivista.
Quando ci troviamo di fronte ad una fattrice con gravidanza a rischio oltre che monitorare attentamente la fase di maturazione fetale, appare di fondamentale importanza organizzare un’adeguata assistenza al parto con l’ausilio di telecamere, allarmi e personale preparato.
La maturazione completa del feto equino, indispensabile per permettere al puledro di affrontare la vita extra-uterina, avviene nell’ultimo mese di gravidanza.
Negli ultimi anni hanno acquisito sempre maggiore importanza gli ausili diagnostici e terapeutici non invasivi, è questo il motivo per cui i biomarker stanno acquisendo sempre maggiore importanza nel processo diagnostico anche in medicina veterinaria.
L’eczema estivo è la più comune condizione pruriginosa cutanea del cavallo.
Le infezioni da parassiti ematici nel cavallo causano l’insorgenza di due sindromi principali di carattere sia acuto che cronico, con ricadute pesanti sulle performance sportive e sulla condizione fisica generale del soggetto colpito
Nell’ultimo mese la movimentazione degli equini sportivi in tutta Europa ha subito delle pesanti limitazioni a causa dei recenti casi di Herpesvirus equino, precisamente di un ceppo neuropatogeno del sierotipo 1 che si è dimostrato particolarmente diffusivo.
In quanto veterinari siamo consapevoli dell’importanza delle malattie virali emergenti, specialmente quando si diffondono rapidamente e le opzioni terapeutiche appaiono limitate.
Nella clinica ippiatrica abbiamo a disposizione alcuni vaccini per la prevenzione di patologie virali e batteriche; questi protocolli vaccinali possono interferire nella diagnostica sierologica anticorpale – vediamo come e per quali malattie.
2020
I virus sono microrganismi essenziali composti da materiale nucleare protetto da un capside proteico ed in alcuni casi da un rivestimento lipidico
È possibile eseguire la coltura del liquido sinoviale da tampone al momento del prelievo, da provetta tappo rosso e da bottiglia da emocoltura, se l’aspetto di questo materiale non indica la presenza di eritrociti, pus e fibrina.
I test batteriologici e micologici sono un ausilio molto importante nella clinica equina di campo.
Il tratto digestivo del cavallo è strutturato per l’utilizzazione ottimale dei derivati vegetali.
L’ippiatra che lavora in campo può trovarsi a dover gestire anche questo tipo di spiacevole diagnostica in soggetti deceduti sia improvvisamente che dopo un iter terapeutico che purtroppo non ha sortito l’effetto sperato.
Il veterinario che si occupa di ortopedia equina non utilizza normalmente gli esami ematologici o dei liquidi cavitari con la stessa frequenza dei colleghi che si occupano di riproduzione, di medicina interna o sportiva; tuttavia il laboratorio può costituire un valido aiuto per le compravendite, le problematiche podoarticolari o le patologie neurologiche, sia nei puledri che nell’adulto.
Nei parti non assistiti ci si può trovare di fronte ad un puledro che sembra clinicamente normale ma che, avendo sofferto durante la nascita o a causa di un ambiente uterino patologico, potrebbe mostrare delle alterazioni clinico-metaboliche importanti dopo le prime 24-48 ore.
Il parto nella cavalla è un momento molto delicato. Numerose problematiche possono infatti presentarsi durante questo evento e in campo è particolarmente importante cercare di anticipare prima possibile l’insorgenza di patologie, per poter gestire al meglio ogni evenienza.
Le sindromi da malassorbimento rappresentano una notevole sfida diagnostica per il veterinario ippiatra poiché possono essere dovute a molte patologie diverse.
Il laboratorio può venire in aiuto al veterinario ippiatra alle prese con le patologie del tratto gastroenterico, nel caso in cui ci siano da prendere decisioni importanti.
Affrontiamo in questa seconda parte la biopsia di alcuni organi cavitari per i quali sono necessarie alcune precauzioni aggiuntive.
Lo sviluppo dell’ecografia nella clinica ippiatrica negli ultimi anni, agevolata dal notevole miglioramento tecnologico degli ecografi portatili e dalle sempre più innovative tecniche bioptiche per i vari apparati, rendono la diagnostica citoistologica sempre più agevole, anche per gli organi interni, solitamente poco accessibili per questi animali di grandi dimensioni.
2019
La dermatite atopica (AD) e l'ipersensibilità alla puntura di insetto (IBH) sono malattie allergiche mediate dalle IgE, rivolte agli allergeni ambientali o alla saliva degli insetti.
Prendiamo in considerazione come eseguire una centesi e come raccogliere materiale diagnostico per i vari distretti accessibili nel cavallo, ovvero addome, torace, articolazioni e liquido cerebrospinale.
La diagnostica di laboratorio dell’apparato respiratorio nella specie equina presenta notevoli difficoltà, dovute principalmente alle caratteristiche fisiche di questo animale
Come precedentemente affermato, non sussistono grossi problemi per una dieta con un eccesso di tenore proteico sia per il cavallo adulto che per la fattrice gravida e/o in lattazione.
La nutrizione equina nella pratica ippiatrica ha acquisito una notevole importanza e la necessità di una efficace integrazione alimentare per il cavallo atleta, l’anziano, la fattrice e il puledro in accrescimento non può prescindere da un adeguato controllo ematologico.
Si tratta di un gruppo di patologie di carattere cronico, caratterizzate dalla presenza di abbondante infiltrato della serie bianca (specialmente eosinofili, ma anche macrofagi e cellule formanti granulomi) in tutti gli strati della parete dell’intestino.
Negli ultimi anni la medicina veterinaria ha affinato notevolmente le proprie capacità diagnostiche, specialmente per quanto concerne le patologie che coinvolgono il sistema immunitario.
Negli ultimi anni ha preso piede anche in Italia l’allevamento dei Camelidi del Sud America.
La medicina sportiva del cavallo ha avuto un notevole sviluppo negli ultimi 20 anni, le performance sportive sono migliorate per tutte le discipline equestri, le possibilità diagnostiche di laboratorio si sono molto ampliate anche grazie alla presenza di sempre nuove tecniche e possibilità investigative
2018
Negli ultimi anni asini, muli e bardotti hanno preso molto piede come utilizzo per passeggiate, pet therapy o semplicemente come animali da compagnia E’ nata quindi l’esigenza di una medicina a loro dedicata in quanto questi animali presentano delle caratteristiche metaboliche e strutturali peculiari che devono essere tenute presenti per una loro ottimale gestione.
Sempre più persone gradiscono la compagnia dei cosiddetti “Miniature horses”, pony molto piccoli, di varie razze (Shetland e Falabella, sono alcuni esempi).
La laminite è una grave patologia delle lamine del piede equino, caratterizzata dalla presenza di importanti processi infiammatori, vascolari e degenerativo-necrotici a carico dei tessuti dello zoccolo.
Tra le razze equine pesanti (TPR, Frisone, Norico, Clydesdale, Shire, ...) possiamo annoverare una particolare incidenza di alcune patologie, in relazione alle differenze di metabolismo e gestione ed anche alle peculiari caratteristiche strutturali di questi soggetti.
In queste situazioni appare di estrema importanza la rapida valutazione dello stato di idratazione del paziente e della compromissione metabolica generale – parametri basilari nel guidare il clinico nella decisione di riferire il paziente in chirurgia o di gestirlo in campo per mezzo di una terapia medica.
Nella clinica ippiatrica ci si trova sovente a dover gestire delle situazioni di emergenza in campo, con limitata possibilità di approfondimenti diagnostici, logistici e di ricovero in clinica, differentemente da quello che succede per i piccoli animali, dove anche un paziente non stabilizzato può, anzi deve, essere trasportato in una struttura adatta.
Vediamo in dettaglio quali esami delle feci possiamo effettuare per il cavallo come ausilio per un efficace controllo degli endoparassiti ma anche per la diagnostica delle più comuni patologie enteriche infiammatorie ed infettive.
Vediamo in dettaglio in che modo la diagnostica di laboratorio può venire in aiuto al veterinario esperto in riproduzione nella gestione delle importanti fasi che interessano la fattrice ed il puledro (gravidanza, parto, periodo neonatale), come discriminante tra situazioni fisiologiche e patologiche.
La malattia di West Nile nel cavallo si è manifestata in Italia una prima volta nel 1998 (Toscana), successivamente dal 2008 con la comparsa di nuovi focolai
2017
Vi sono alcune malattie genetiche specifiche di razza, tutte di carattere autosomico recessivo.
Nella specie equina sono descritte numerose malattie a carattere genetico per le quali fino a pochi anni fa non era disponibile nessun test diagnostico appropriato.
Nella clinica ippiatrica le patologie muscolari e cardiache contribuiscono in maniera sostanziale alla „Sindrome da calo di performance“ del cavallo sportivo.
Nell'allevamento professionare del cavallo così come nell'allevamento amatoriale, l'esame della salute riproduttiva delle cavalle ha un ruolo fondamentale.
Accanto alla classica sindrome colica di varia origine e tipologia, nel cavallo possiamo riscontrare una serie di patologie enteriche acute/croniche per le quali la diagnostica di laboratorio appare di primaria importanza.
Le malattie epatiche possono avere carattere acuto o cronico e sono associate molto spesso ad una sintomatologia aspecifica
Le malattie parassitarie interne negli equini interessano perlopiù l‘apparato gastroenterico e respiratorio e possono colpire soggetti di ogni età, con predilezione per gli yearlings ed i soggetti anziani oltre i 20 anni.
Nell‘ambito della diagnostica delle malattie infettive abbiamo a disposizione una metodica di ricerca ed amplificazione del materiale genetico relativo all‘agente eziologico causa di malattia: la PCR (Polymerase Chain Reaction).
Per la diagnostica delle malattie infettive e parassitarie possiamo avvalerci di molteplici metodiche che utilizzano siero, plasma od altri materiali, differenti di volta in volta a seconda delle caratteristiche peculiari della malattia che costituisce il sospetto diagnostico.
La dermatologia equina ha avuto un notevole sviluppo negli ultimi anni grazie anche al continuo affinarsi di nuove metodiche di laboratorio che rendono possibile una diagnosi eziologica sempre più accurata, base per l’impostazione di un’idonea terapia.
Il termine iperlipemia o iperlipidemia indica un’abnorme concentrazione nel sangue di lipidi che potrebbe indicare un grave disordine metabolico.
L’anemia può essere sintomo di numerose patologie, è quindi molto importante una sua precisa caratterizzazione attraverso la diagnostica di laboratorio che si avvale dell’esame emocromo-citometrico completo con l’esame visivo dello striscio ematico, indispensabile per un controllo morfologico accurato delle popolazioni ematiche cellulari riscontrate.
2016
Un castrone di razza Trakehnen (Prussiano Orientale) di 4 anni ha mostrato una formazione nodulare in corrispondenza della narice sinistra.
Le ulcere gastriche possono colpire cavalli di ogni razza ed età, sono predisposti soprattutto i purosangue ed i soggetti sportivi a causa degli adattamenti alimentari e manageriali necessari allo svolgimento dell’attività equestre e della vita di scuderia
Il progressivo invecchiamento della popolazione equina che si sta verificando negli ultimi anni, grazie alla miglior alimentazione e cura di questi animali, ha portato il veterinario clinico a rilevare con sempre maggior frequenza alcune patologie tipiche del cavallo “maturo” (con più di 15 anni) od “anziano” (con più di 20 anni).
In una clinica è stato portato un castrone a sangue caldo di 18 anni con la seguente anamnesi: perdita di peso, anoressia, spesso letargia, il tutto da circa 6 mesi.
La giumenta di nome Elisa, 11 anni di età, di razza KWPN, da diverse settimane manifesta sempre maggior riluttanza al lavoro ed al movimento accompagnate da una chiara diminuzione di assunzione di cibo.
La sindrome metabolica con insulino resistenza è una patologia caratteristica del cavallo anziano od obeso, dovuta ad una generale minor risposta dei recettori dell’insulina a livello cellulare e conseguente disordine che coinvolge il metabolismo energetico dei carboidrati e dei lipidi
L’aspettativa di vita dei nostri cavalli “domestici” è in continuo aumento, l’equino assume sempre di più le caratteristiche di animale da compagnia piuttosto che mero soggetto sportivo o zootecnico, di conseguenza appare di fondamentale importanza la comprensione delle modificazioni metaboliche, alimentari e gestionali che permettono un invecchiamento sereno di questi nostri compagni di vita.
Il proprietario di un Haflinger castrone di 7 anni di età, ha riferito che il suo cavallo soffre di prurito da circa 2 anni e mezzo.
Il cavallo castrato „Silver Star“ di 15 anni, razza Morgan, proveniente dalla zona germanica di Baden-Württemberg, pochi giorni dopo una lunga passeggiata ha mostrato andatura rigida e una sempre maggiore riluttanza al movimento.
Nel maschio intero possiamo riscontrare la presenza di numerosi ormoni di natura sessuale: non solo testosterone e ossitocina, ma anche inibina ed activina (regolano la spermiogenesi) e piccole dosi di estrogeni.
Esaminiamo le principali malattie infettive che possono manifestarsi nel puledro e come le moderne tecniche di laboratorio ne permettano una rapida diagnosi eziologica, ...
Un recente sondaggio nel Regno Unito (“National Equine Health Survey”) ha collocato le patologie respiratorie al quarto posto delle più comuni preoccupazioni per la salute da parte dei proprietari di cavalli.
La diagnostica di laboratorio nel il puledro assume una notevole importanza in questi animali.
Per “calo della performance nel cavallo sportivo” si intende un generale calo di rendimento delle prestazioni agonistiche in assenza di segni clinici chiari relativi a zoppie, dolorabilità muscolari o patologie evidenti a carico degli apparati cardiorespiratorio ed articolare, in soggetti che precedentemente risultavano performanti.
La neurologia equina ha avuto una notevole progressione negli ultimi anni, grazie anche allo sviluppo di evoluti ausili diagnostici a disposizione del moderno ippiatra, ad esempio gli apparecchi radiografici ed ecografici che permettono esami approfonditi come la contrastografia, l’ecografia neurologica e nei casi più complessi perfino la TAC e la risonanza magnetica
La diagnostica delle malattie infettive si basa sia sull’isolamento diretto dell’agente eziologico (virale, batterico o parassitario)...
2015
Nel cavallo l‘apparato respiratorio assume una notevole importanza per la performance atletica del soggetto sportivo.
Per poliuria si intende un aumento della quantità di urina prodotta superiore al 5% in peso corporeo al giorno (20-25 lt circa al giorno), per polidipsia invece si intende un aumento dell’assunzione di acqua oltre il 10% del peso corporeo (50 lt circa al giorno) in assenza di sintomi...
Quali possono essere i sintomi caratteristici che fanno pensare ad una patologia coinvolgente l’apparato urinario in un cavallo?
Negli ultimi anni i monitoraggi ormonali hanno acquisito molta importanza nella gestione del ciclo estrale della fattrice vuota e nella gestione della gravidanza a rischio, ...
La sintomatologia tipica di questa patologia, caratteristica del soggetto maturo / anziano con appetito conservato comprende: ...
2014
Finita la stagione di monta, l’ attività del veterinario che si occupa di riproduzione equina si focalizza sulla gestione delle cavalle rimaste vuote.